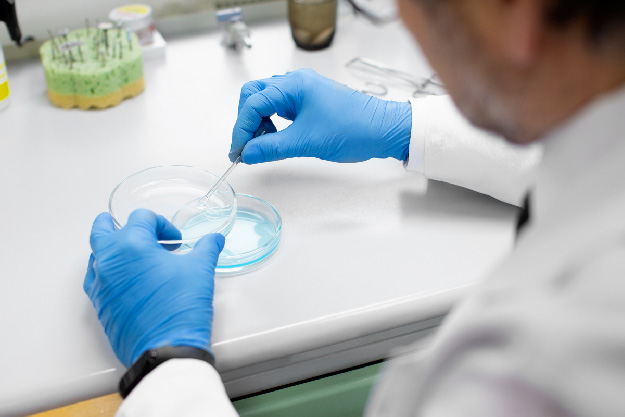

Até o dia 20 de agosto, a Unijuí recebe inscrições para o curso de “Antibiograma: da elaboração ao laudo”. Com duração de 12h, a qualificação é direcionada aos estudantes e profissionais da área da saúde e ciências biológicas.
Este é um curso téorico-prático acerca da elaboração, interpretação e laudo laboratorial do antibiograma.
Interessados podem se inscrever em unijui.edu.br/educacaocontinuada. O curso será realizado de forma presencial no campus Ijuí, nos dias 1º de setembro (das 18h às 22h) e 2 de setembro (das 8h às 12h e das 13h às 17h).
Mais informações podem ser obtidas na página do curso, pelo telefone (55) 3332-0553, WhatsApp (55) 99180-6755 ou pelo e-mail estude@unijui.edu.br.